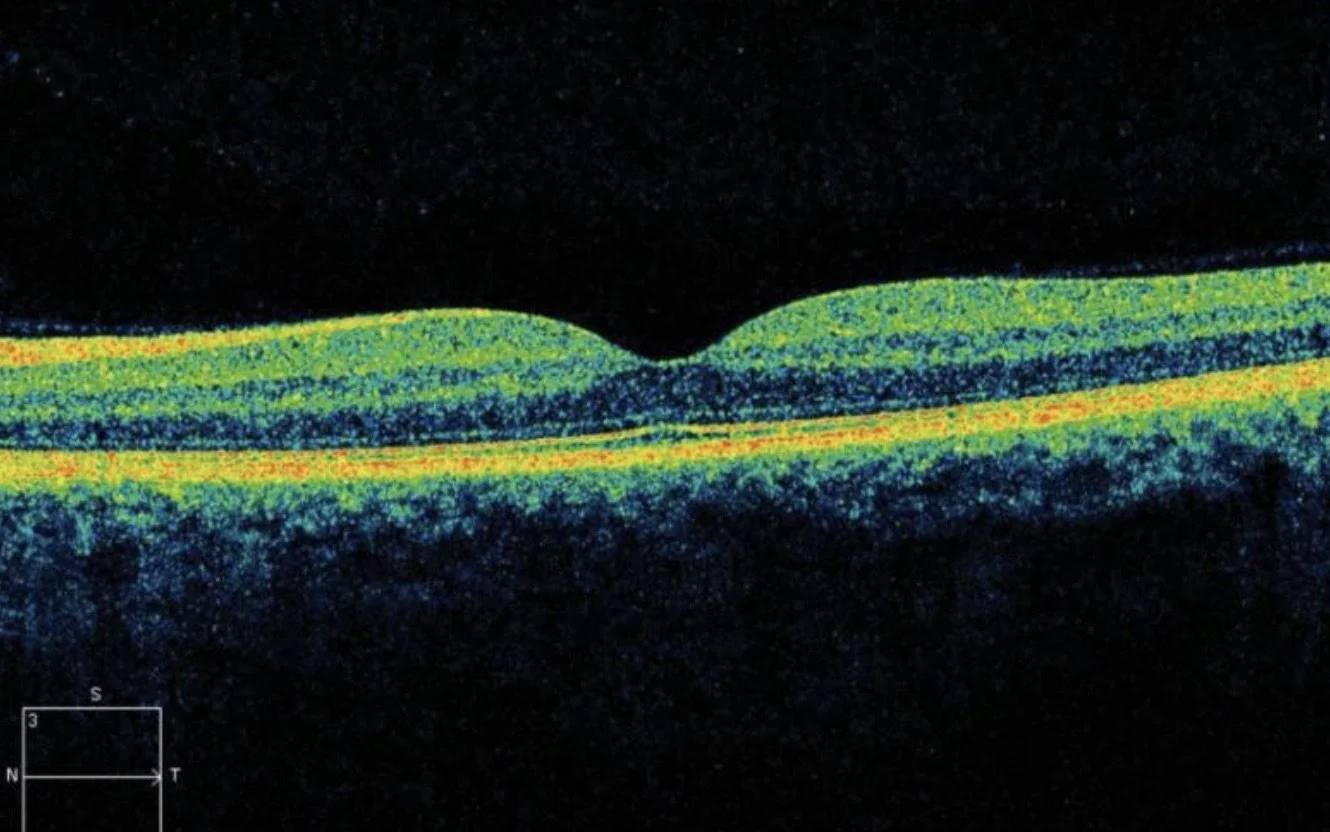

Advanced Eye Exam

Our advanced eye exam is one of the most comprehensive examinations available in Aberdeen.
It comprises of a OCT (ocular coherence tomography) and ultra wide optomap image (200 degree photo/80% of retina).
Both of these are painless procedures, they do not require the use of any drops, but they use light to give us the best images of your eyes.
OCT is the best way to detect eye disease at the earliest possible opportunity.
It takes a 3D scan of the retina, allowing us to see the surface of the retina as well as the layers underneath.
This allows us to pick up early subtle changes in the retina which would otherwise go undetected.
Over time, we can build up a picture of your eye health and see any changes before you have any problems with your vision.
An ultra wide optomap images takes a 200 degree photograph of the retina, compared to the standard 45 degree photo taken as part of the NHS eye exam.
This allows us to view much more of the retina than ever before.
These tests are particularly useful in detecting glaucoma, age-related macular degeneration, diabetes, macular holes, diabetes, high blood pressure, posterior vitreous detachments, retinal tumors, retinal tears/holes and peripheral retinal degernations.
For only £45 you can have this done at your appointment, just ask your optometrist.
